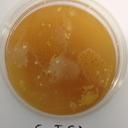
brent gavin - @Sayantipikoako - Twitter

Brent Gavin Enderson - @BEnderson30594
yatağının yanındaki masanın üstünde kalmıştı, Büyük Trisha’dan

Brent Gavin - @brent_gavin1

Brent Gavin - @BrentGavin2
Tall kids

tolen tino - @BrentGavin11
Brent_t111
Sponsored by SpokeoPaid Service
Brent B Gavin
I*****@gmail.com — (316) 633-****
***** E 15th St, Baxter Springs, KS
Brent W Gavin
G*****@aol.com — (310) 871-****
***** N Doheny Dr, Apt 10, West Hollywood, CA
Brent Gavin
(865) 483-****
***** S Jefferson Cir, Oak Ridge, TN
Sponsored by SpokeoPaid Service
Brent Gavin
Sponsored by PeopleLookerPaid Service
Search for contact info, city & state history, relatives, jobs, education & more
Search public records

Brent Collopy Gavin Fouracres
Hi there, want more beer?

brent gavin - @cristoffe_123
60 followers

😎. - @brentgavin
4 followers

Another - @brent_gavin
4 followers

jenncharlize - @brentgavin37
3 followers

Marvie John Manongso - @brentgavin29
1 follower

brentgavin0 - @brentgavin0
4 followers

BrentGavin2024 - @brentgavin2024
1 follower

GAVIN🇵🇭🇹🇼 - @brenttgavin
37 followers

Michelle Silvestre - @gavinbrentbenish
BERNARD💙
GAVINBRENTBENISH♡
44 followers
Brent Gavin Zamora - @brentgavinzamora5297
3 subscribers
Gavin Brent - @gavinbrent7249
2 subscribers
Gavin brent - @gavinbrent9563
27 subscribers

Brent Gavin
Land Planner Co-op - Fischer Homes

Brent Gavin




Brent Gavin
Australian Institute of Fitness - Greater Sydney Area
Education: Australian Institute of Fitness

Paul Bailey, MBA, HMCC, SES

Anjuli Bhatia
Small Business Owner - Canada Revealed

Halina Teasdale

Scott Macmillan
Vacation Advisor - Fresh Tracks Canada
Experience: Fresh Tracks Canada ...

Sofia Montezo Campian
Atlas Obscura
Education: University of Toronto ...

Bobbi Willms
Guest Resolutions - Globus family of brands

Joni Krueger


Kavan Kumar
Events and Industry Relations Specialist
Experience: Thompson Okanagan Tourism Association (TOTA) ...

Lana Day

Karen Skirten
Marketing & Sales Manager

John Hewson
Brent Gavin
Sponsored by PeopleLookerPaid Service
Search for Brent Gavin's city and state history
Search address historyClash of the two Comptons| Stories from the Turnpike
PA Turnpike - Sun, 14 May 2023
Lawrence Roark Jr. Obituary 2016
Newcomer Funeral Home - Mon, 19 Sep 2016
WORLD CLASS
PrimePublishers.com - Wed, 21 Jul 2021
Man jailed for punch that left friend brain damaged
Jersey Evening Post - Sat, 18 Apr 2015
Obituary for Oscar Maynard Miller Sr
Bahamas Tribune - Thu, 19 Dec 2013
Obituary for Dora Christina Jones-Dean
Bahamas Tribune - Sat, 24 Aug 2013

Brent Gavin - @brentgavin302
0 followers

Brent Gavin - @bgavin1805
0 followers

Brent Gavin - @bjgavin2
40 followers

Brent Gavin - @brentgavin
0 followers

Brent Gavin - @brentgav7
0 followers

Brent Gavin Bucey - @bgbucey
0 followers

Brent Gavin - @brentgavin23
0 followers

Gavin Brents - @gavinbrents
0 followers

Gavin Brent - @gavin_brent
0 followers

Brent McGavin - @brentmcgavin
0 followers

Gavin Brent De Guzman - @gavinbrentd
0 followers
Brent Gavin - Address & Phone Number - Whitepages
View Brent Gavin results including current phone number, address, relatives, background check report, and property record with Whitepages.
Brent Gavin Joins MSP as Landscape Architecture co-op
Please join us in welcoming Brent Gavin, MSP Landscape Architecture co-op. Brent’s responsibilities include working on landscape architecture drawings, planning, and research for the department.
Brent Gavin - Player Profile
Summer 2024 Wildcats - Baseball. Player Profile ...
Brent Gavin Urban Planning Portfolio by BrentGavin
Brent Gavin PLAN 1012 One project I was tasked with was representing what the Fairmount neighborhoods look like South Fairmount’s eastern edge through cross sections and elevations. 3D Model of...
Brent Francis Gavin | 53 | N 27th Ave W, Duluth, MN
Brent Francis Gavin, age 53, lives in Duluth, MN. Find their contact information including current home address, phone number 218-525-0949, background check reports, and property record …
2023 Portfolio - Brent Gavin by BrentGavin - Issuu
Read 2023 Portfolio - Brent Gavin by BrentGavin on Issuu and browse thousands of other publications on our platform. Start here!
Brent Gavin - Tourism Industry Association of Canada
150 Condor Rd Whitehorse, YT Canada Y1A 0M7. Site Map; Privacy Policy; Terms and Conditions; CTA Judges Login; Contact (613) 238-7887
Brent Gavin (18 matches): Phone Number, Email, Address - Spokeo
18 records for Brent Gavin. Find Brent Gavin’s phone number, address, and email on Spokeo, the leading online directory for contact information.
Brent Gavin: Business Profiles | ZoomInfo.com
Find contact and company information for business people in our free business information database. This directory covers Brent Gavin.




















































